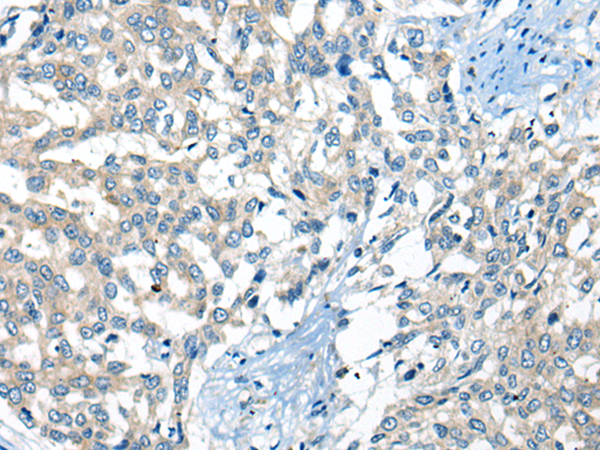
一抗

中文名稱: 兔抗NIBAN3多克隆抗體
英文名稱: Anti-NIBAN3 rabbit polyclonal antibody
別 名: niban apoptosis regulator 3; BCNP1; FAM129C
相關(guān)類別: 一抗
儲 存: 冷凍(-20℃)
宿 主: Rabbit
抗 原: NIBAN3
反應(yīng)種屬: Human
標(biāo) 記 物: Unconjugate
克隆類型: rabbit polyclonal
技術(shù)規(guī)格
|
Background: |
FAM129C, also known as BCNP1, BCNP1 is a 697 amino acid protein that belongs to the Niban family. Specifically expressed in B-lymphocytes, BCNP1 exists as five alternatively spliced isoforms. BCNP1 is highly expressed in B-cell malignancies, lymph node and spleen, with little to no expression in other tissues, including other hemopoietic tissues. The gene encoding the BCNP1 protein maps to human chromosome 19p13.11. Consisting of around 63 million bases with over 1,400 genes, chromosome 19 makes up over 2% of human genomic DNA. Chromosome 19 includes a diversity of interesting genes and is recognized for having the greatest gene density of the human chromosomes. It is the genetic home for a number of immunoglobulin superfamily members including the killer cell and leukocyte Ig-like receptors, a number of ICAMs, the CEACAM and PSG family, and Fc? receptors. Key genes for eye color and hair color also map to chromosome 19. |
|
Applications: |
ELISA, IHC |
|
Name of antibody: |
NIBAN3 |
|
Immunogen: |
Synthetic peptide of human NIBAN3 |
|
Full name: |
niban apoptosis regulator 3 |
|
Synonyms: |
BCNP1; FAM129C |
|
SwissProt: |
Q86XR2 |
|
IHC positive control: |
Human liver cancer |
|
IHC Recommend dilution: |
20-100 |

 購物車
購物車 幫助
幫助
 021-54845833/15800441009
021-54845833/15800441009